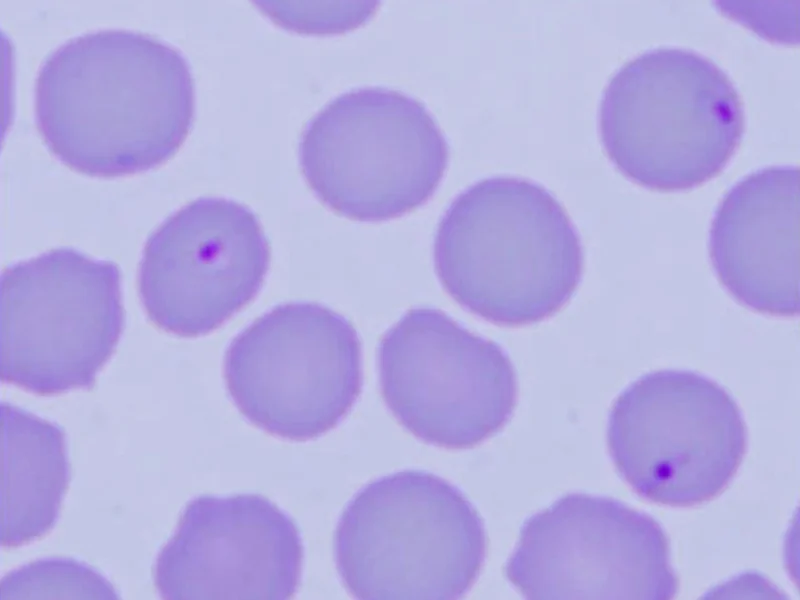

Bobcat fever natural treatment store
Bobcat fever natural treatment store, Bobcat Fever in Cats Cytauxzoonosis Rock N Country Rock n Country Veterinary Services store
4.6 (1240)
Limited-Time Special
$39.00 (50% off) $78
Color:
Size: Please select
Product Details
Web ID: 1247
Product Name: Bobcat fever natural treatment store
Bobcat Fever Protect Your Cat Against Cytauxzoonosis store, Treating bobcat fever in domestic cats Oklahoma State University store, Bobcat fever Vet In Lebanon Lebanon Animal Hospital store, Early detection and treatment are key for cats here to survive bobcat fever Ozark County Times store, Proper treatment can help cats survive bobcat fever News tahlequahdailypress store, Proper treatment can help cats survive bobcat fever News tahlequahdailypress store, Mew Cat Rescue Bobcat Fever is a severe tick borne disease that is often fatal to cats. The disease is prevalent in southern states such as Arkansas where Bobcats and the store, Treating bobcat fever in domestic cats Oklahoma State University store, What is Cytauxzoonosis AKA Bobcat Fever Vet In Lebanon Lebanon Animal Hospital store, Union Hill Veterinary Hospital Dr Higdon diagnosed a case of Cytauxzoon or Bobcat Fever at our clinic earlier this week. There is no treatment for this disease that is spread to store, Proper treatment can help cats survive bobcat fever News tahlequahdailypress store, Bobcat Fever Infects Midwest Cat store, 434KB 2001 null null null 12 null null 12 2003 null ppkoui1xADGiYM store, Bobcat Fever Our Vet Discusses Signs Causes Treatment Catster store, PSA Bobcat fever is a brutal and violent disease. Even with two different expensive and consistent treatments my cat still caught ticks and this is ultimately what took him from us. I had no idea store, Bobcat Fever Danger for Housecats Mannford Animal Clinic store, Bobcat Fever store, Your Cat May Not Survive Bobcat Fever Animal Medical Center Of Tyler store, What is bobcat fever and how is it affecting Southern Illinoisans Local News thesouthern store, Bobcat Fever is taking its toll on domestic cats this summer at the Lake of the Ozarks Newsroom kjluradio store, Bobcat Fever in Cats Cytauxzoonosis Rock N Country Rock n Country Veterinary Services store, Bobcat Fever Danger for Housecats Mannford Animal Clinic store, Bobcat Fever in Cats Cytauxzoonosis Rock N Country Rock n Country Veterinary Services store, Bobcat Fever Our Vet Discusses Signs Causes Treatment Catster store, Cytauxzoonosis Bobcat Fever whiskerDocs store, What is Cytauxzoonosis AKA Bobcat Fever Vet In Lebanon Lebanon Animal Hospital store, Bobcat Fever Our Vet Discusses Signs Causes Treatment Catster store, Home Remedies for Cat Fever Keeping Your Feline Cool and Comfy store, Bobcat Fever in Cats Cytauxzoonosis Rock N Country Rock n Country Veterinary Services store, Bobcat fever Vet In Lebanon Lebanon Animal Hospital store, Bobcat fever Know the signs and get help Eureka Springs Independent store, bobcattickfeversurvivor TikTok store, Prayers for my Bubbers That he makes it back home to me. He s my baby I lost his father in May to Bobcat fever that broke me He s the only thing I have left of him He looks just like him store, Proper treatment can help cats survive bobcat fever News tahlequahdailypress store, Tick Borne disease poses threat to cats Living elkvalleytimes store.
Bobcat Fever Protect Your Cat Against Cytauxzoonosis store, Treating bobcat fever in domestic cats Oklahoma State University store, Bobcat fever Vet In Lebanon Lebanon Animal Hospital store, Early detection and treatment are key for cats here to survive bobcat fever Ozark County Times store, Proper treatment can help cats survive bobcat fever News tahlequahdailypress store, Proper treatment can help cats survive bobcat fever News tahlequahdailypress store, Mew Cat Rescue Bobcat Fever is a severe tick borne disease that is often fatal to cats. The disease is prevalent in southern states such as Arkansas where Bobcats and the store, Treating bobcat fever in domestic cats Oklahoma State University store, What is Cytauxzoonosis AKA Bobcat Fever Vet In Lebanon Lebanon Animal Hospital store, Union Hill Veterinary Hospital Dr Higdon diagnosed a case of Cytauxzoon or Bobcat Fever at our clinic earlier this week. There is no treatment for this disease that is spread to store, Proper treatment can help cats survive bobcat fever News tahlequahdailypress store, Bobcat Fever Infects Midwest Cat store, 434KB 2001 null null null 12 null null 12 2003 null ppkoui1xADGiYM store, Bobcat Fever Our Vet Discusses Signs Causes Treatment Catster store, PSA Bobcat fever is a brutal and violent disease. Even with two different expensive and consistent treatments my cat still caught ticks and this is ultimately what took him from us. I had no idea store, Bobcat Fever Danger for Housecats Mannford Animal Clinic store, Bobcat Fever store, Your Cat May Not Survive Bobcat Fever Animal Medical Center Of Tyler store, What is bobcat fever and how is it affecting Southern Illinoisans Local News thesouthern store, Bobcat Fever is taking its toll on domestic cats this summer at the Lake of the Ozarks Newsroom kjluradio store, Bobcat Fever in Cats Cytauxzoonosis Rock N Country Rock n Country Veterinary Services store, Bobcat Fever Danger for Housecats Mannford Animal Clinic store, Bobcat Fever in Cats Cytauxzoonosis Rock N Country Rock n Country Veterinary Services store, Bobcat Fever Our Vet Discusses Signs Causes Treatment Catster store, Cytauxzoonosis Bobcat Fever whiskerDocs store, What is Cytauxzoonosis AKA Bobcat Fever Vet In Lebanon Lebanon Animal Hospital store, Bobcat Fever Our Vet Discusses Signs Causes Treatment Catster store, Home Remedies for Cat Fever Keeping Your Feline Cool and Comfy store, Bobcat Fever in Cats Cytauxzoonosis Rock N Country Rock n Country Veterinary Services store, Bobcat fever Vet In Lebanon Lebanon Animal Hospital store, Bobcat fever Know the signs and get help Eureka Springs Independent store, bobcattickfeversurvivor TikTok store, Prayers for my Bubbers That he makes it back home to me. He s my baby I lost his father in May to Bobcat fever that broke me He s the only thing I have left of him He looks just like him store, Proper treatment can help cats survive bobcat fever News tahlequahdailypress store, Tick Borne disease poses threat to cats Living elkvalleytimes store.